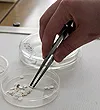
vvv1.jpeg

Руководитель: доцент кафедры Павлов Кирилл Игоревич, к.м.н.
Датой основания кружка принято считать 29 марта 1925 года, кода в университетском корпусе по улице Ленинградской прошло первое заседание кружка, на котором присутствовали 11 человек и на котором был представлен доклад товарища Левиной на очень важную в послевоенное время тему «Эпидемиология и этиология сыпного тифа».
То поколение знало ужас сыпного тифа, полыхавшего в годы первой мировой и гражданской войны, а потому на заседании завязалась оживленная дискуссия, в которой точки над “i” расставлял первый заведующий кафедрой Борис Яковлевич Эльберт.
Кафедральные архивы хранят чудом уцелевший протокол первого заседания студенческого научного кружка с ремарками Б. Я. Эльберта. Держа в руках протокол первого заседания, с благоговением перечитываешь имена первых кружковцев: т. Любецкая, т. Каплан, т. Голуб, т. Беленький, т. Айзенман, т. Липманова, – и первых вопросов, прозвучавших на кружке: «Возбудитель сыпного тифа относится к фильтрующимся вирусам? Можно ли заразиться сыпным тифом энтерально? Существует ли естественный иммунитет при сыпном тифе? Были ли попытки специфической профилактики сыпного тифа? Появляется ли сыпь у животных? Нужна ли непременно рана кожи, чтобы произошло заражение?».
К сожалению, мы не знаем о дальнейшей судьбе первых кружковцев, но, надеемся, что их жажда знаний, их неподдельный интерес к медицинской науке были путеводной звездой, сохранившей их в нелегкие времена, выпавшие на долю того поколения, надеемся, что они прожили долгую и счастливую жизнь.
Традиционной в работе кружка является преемственность, когда кружковцы перерастают в научных руководителей, а затем их кружковцы руководят работой других. В 50-е годы в кружке работали студенты А.П. Красильников и Л.С. Змушко.
Став сотрудниками кафедры, они руководили работой студентов И.А. Крылова, Л.Г. Борткевич, В.А. Молочко, А.А. Адарченко, Л.П. Титова, Г.А. Скорохода, В.П. Антипенко, Т.А. Канашковой, которые, в свою очередь, руководили работой студентов Т.Р. Романовской, Ж.Г. Зайко (Шабан), Е.Ю. Юрчук (Кирильчик), Д.А. Черношея, В.А. Горбунова, В.В. Слизень, Т.Г. Литвинович (Адамович), Е.С.Носовой, у которых к настоящему времени появляются свои питомцы (Маркевич В.В., Тарасюк В.В., Закер С.Б.). Кружковцами кафедры защищено более 15 кандидатских диссертаций. Бывшие кружковцы заведуют кафедрами, научными лабораториями, работают преподавателями на кафедрах, в НИИ РБ и других стран.
За период 1990 до 2011 года 52работы награждено дипломами и грамотами. Результаты НИР активно внедряются в учебный процесс. Так, за указанный период акты внедрения результатов НИР в учебный процесс получили более 80 студентов, результаты около 45 студенческих работ используются в научно-исследовательских лабораториях, работа Никитина Д. и Забавского Д. “Модификация метода определения функциональной активности альтернативно пути активации комплемента по 50% гемолизу” оформлена как рационализаторское предложение (1994 г.).
На протяжении многих лет в течение учебного года в работе кружка в среднем принимает участие около 40 студентов, которые делают сообщения и доклады на конференции, ежемесячных заседаниях кружка, проводят экспериментальные исследования, участвуют в олимпиаде по микробиологии.
На заседаниях кружка, проводимых ежемесячно, студенты имеют возможность не только выступать с сообщениями, но и апробировать доклады, с которыми они будут выступать на ежегодной конференции БГМУ.
Приходящие на кафедру студенты могут выбрать одно из направлений и выполнить:
- Теоретическое исследование по одной из актуальных медицинских проблем;
- Экспериментальное исследование в рамках одной из научно-исследовательских тем, выполняемых сотрудниками кафедры.
Полученные в ходе теоретических и экспериментальных исследований данные студенты могут представить:
- в виде доклада: на заседаниях кружка; на ежегодной научной студенческой конференции в БГМУ; на научных студенческих конференциях в РБ и странах ближнего зарубежья (РФ, Украина, Молдова и т.д.).
- в виде статьи в сборниках трудов молодых ученых и студентов БГМУ, других образовательных учреждений РБ и стран ближнего зарубежья;
- в виде студенческой научной работы на Республиканский конкурс научных студенческих работ.
- полученные в ходе теоретических и экспериментальных исследований данные студенты могут внедрить в учебный процесс кафедры и оформить акт внедрения.
Помощь в выборе актуальных проблем микробиологической науки для выполнения теоретических исследований могут оказать как руководитель кружка, так и научный руководитель, в качестве которого могут выступать преподаватели кафедры, сотрудники лаборатории внутрибольничных инфекций НИЧ (ЦНИЛ) БГМУ, а также сотрудники РНПЦ эпидемиологии и микробиологии МЗ РБ, сотрудники профильных лабораторий больниц и ЦГЭ и ОЗ.
Отчет о работе СНК 2024/2025
Положение об Олимпиаде
Результаты 79 научно-практической конференции студентов и молодых ученых с международным участием «Актуальные проблемы современной медицины и фармации -2025»
Результаты Олимпиады по микробиологии, вирусологии, иммунологии в 2024 году
Ежегодно на кафедре перед зимней сессией проводится Олимпиада по предмету. Принять участие в ней могут все желающие, у кого коллоквиальные оценки не ниже 7 баллов.